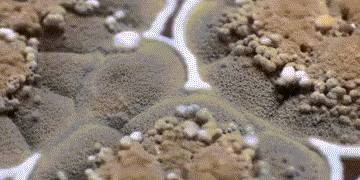

最傷肝的水果!86歲阿嬤常吃「晚年患肝癌」 很多老年人節省愛買:勸你管住嘴
每個人家裡都有一個勤儉節約的爺爺奶奶,他們有一個共同的口頭禪:你們年輕人太浪費了,以前鬧飢荒的時候我們連樹皮都啃......
今年86的李奶奶也是一樣,平時最喜歡的事情就是每天去菜市場撿最後撤攤時候的促銷水果蔬菜。
因為價格十分便宜,所以每次李奶奶都是整袋整袋往家買,很多時候還會發霉,即便這樣,李奶奶也捨不得扔,能吃的部分照樣吃。
家人勸了很多次,李奶奶覺得自己吃了也沒啥毛病,所以習慣一直都保持著。

但是在最近的一次體檢中,李奶奶被告知甲胎蛋白490,確診為肝癌。鑒於年齡太大,醫生建議保守治療。
Advertisements
兒女痛哭,本該安享晚年,怎麼好端端的就患上肝癌了呢?
在進一步溝通中,醫生了解到了李奶奶的日常生活習慣,這才知道原來李奶奶的病情是因為這種水果吃太多!

Advertisements
劉奶奶患上肝癌的原因,和她經常買的促銷水果有關係!
很多人都有這樣的習慣,一顆水果上有些小霉點,覺得剜掉霉點其他部分就是乾淨的,照吃不誤。
其實水果是一個完整的生命系統,發霉後會產生有害的微生物和黴菌,它們會像癌細胞一樣擴散到水果的每個地方,也就是說看起來沒壞的部分其實也布滿細菌!
尤其是一種叫黃麴黴毒素的極強劇毒物質。其中的黃麴黴毒素B1,毒性是砒霜的68倍,是氰化鉀的10倍,對肝臟組織的破壞性極強。
有研究表明,這種物質攝入1毫克就可能致癌,一次性攝入20毫克就能致命!
除了發霉的水果,霉變玉米、花生、瓜子、豆類,長時間泡發的木耳等都不可食用,還有家裡的筷子、案板發霉,請及時更換。
總之,要吃進肚子里的東西,發霉了就扔掉!!!
Advertisements

平時毒素積累太多,自然肝毒就會加深,別以為肝不叫喚就沒事,它會在身上各個地方有「求救信號」,發早得早就有機會遠離肝癌。
Advertisements
皮膚粗糙長斑
肝主疏泄,負責幫助人體調節氣血水液,維持人體代謝正常。肝氣疏泄正常,氣血就不會瘀滯,水液也需要跟隨氣機流通,氣機暢通無阻,水濕就能正常排出體外,臉上也不會長斑點暗瘡。
反之則色斑、暗瘡此起彼伏,不得消停。此外,肝不好,維生素類代謝會出現異常,而缺乏維生素可致夜盲、皮膚粗糙、浮腫等癥狀。
2鼻出血、牙齦出血
實際上刷牙出現牙齦出血的現象是很常見的,也是大多數人都會有的,一般是因為上火導致的。
但是如果刷牙出現牙齦出血在在進行了下火的手段,但是出血的癥狀還繼續出現,那可能就是肝不好導致的了,這個時候就需要去醫院進行檢查了。

3、白天嗜睡或者睡很久才醒
一般情況下,睡眠到一定時間就會醒來。但很多有慢性肝病的患者,常常會出現嗜睡的情況。慢性肝病患者在白天有嗜睡的表現,但是到了晚上卻又睡不著,是因為肝炎病毒的影響,導致中性粒細胞核嗜酸性粒細胞水平變高,出現睡眠異常和障礙。
4腳底紋路增多
腳掌紋路增多,且變得明顯,除了要做好腳部保暖,還要開始保養肝臟。
因肝藏血,負責給人體解毒,排出毒素,而一旦肝臟受損,能力下降,血液健康也會受到影響,無法更好的滋養腳部所致。
